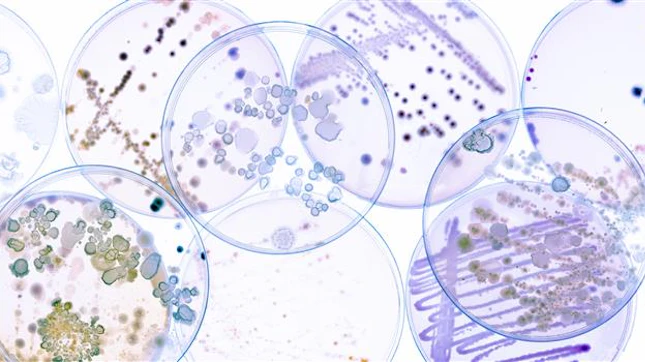
Laboratório de Microbiologia SGS Portugal Laboratório de Microbiologia SGS Portugal

O que procura?
Loading component...
Alguns tópicos que lhe podem interessar

Loading...

SGS Academy Portugal
A aprendizagem ao longo da vida e o desenvolvimento de novas competências são dois fatores decisivos para o sucesso das pessoas, das organizações e da sociedade. A SGS Academy Portugal está aqui para o acompanhar nesta viagem.
Loading...